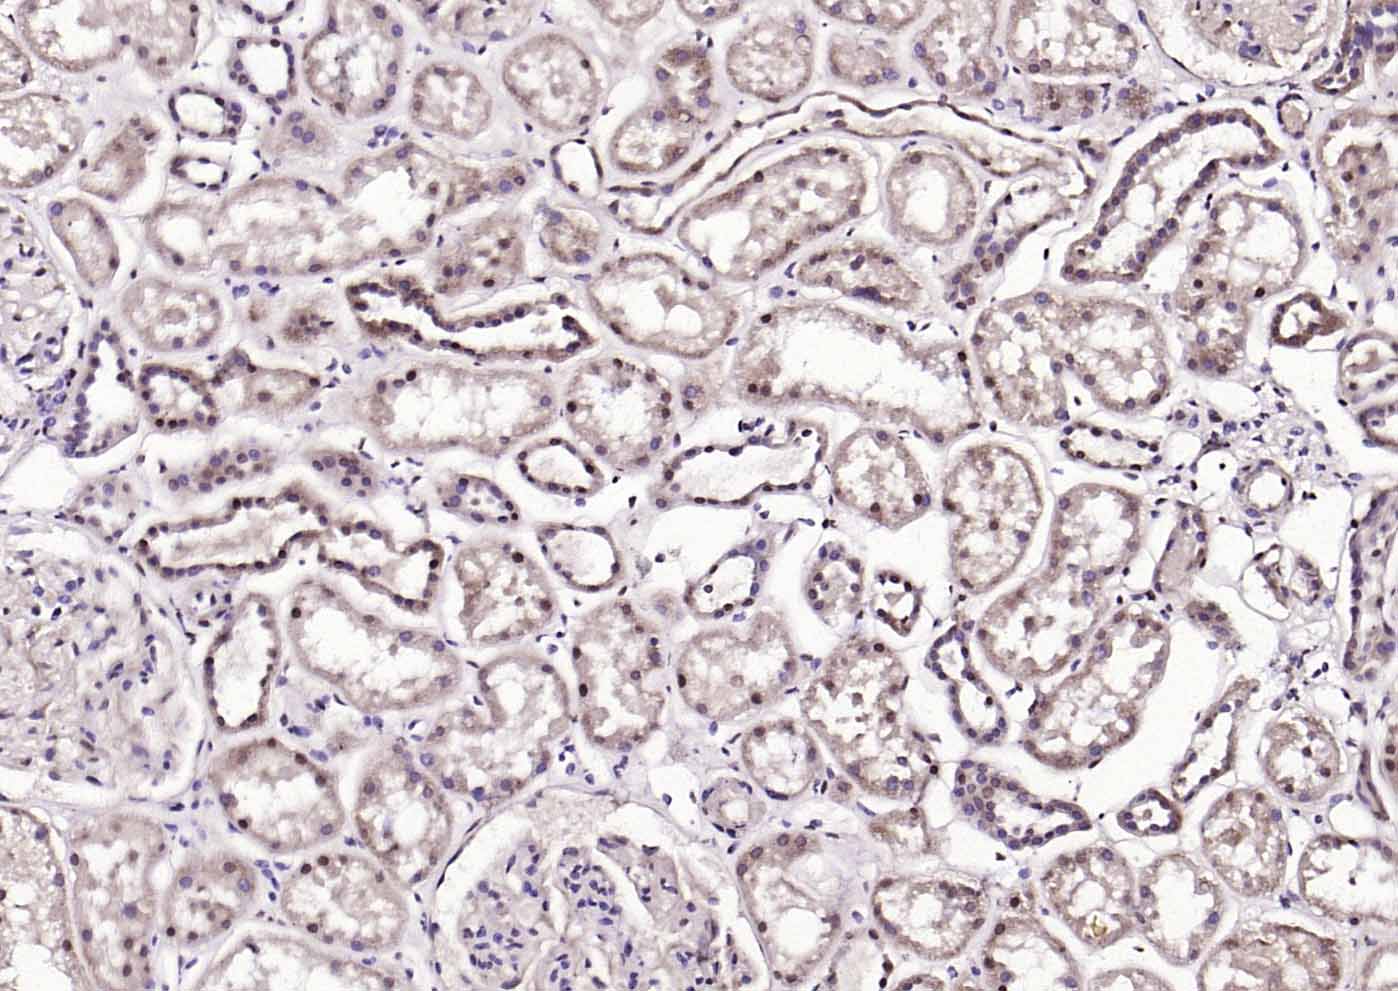
AMPK beta 1/PRKAB1 Rabbit pAb(

相关产品推荐更多 >

phospho-VEGF receptor 2 (Tyr996) Rabbit pAb, BF594 conjugated(bs-3470R-BF594)-100ul
¥2980
NES/Kallikrein 10 Rabbit pAb(bs-24271R)-50ul/100ul/200ul
¥1180
KIAA1467 Rabbit pAb(bs-17008R)-50ul/100ul/200ul
¥1180
CLSTN2 Rabbit pAb(bs-11339R)-50ul/100ul/200ul
¥1180
FOXO1 Rabbit pAb, APC conjugated(bs-2537R-APC)-100ul
¥2980
万千商家帮你免费找货
0 人在求购买到急需产品
- 详细信息
- 文献和实验
- 技术资料
- 应用范围:
产品信息以Bioss网站为准
- 规格:
50ul/100ul/200ul
| 规格: | 50ul | 产品价格: | ¥1180.0 |
|---|---|---|---|
| 规格: | 100ul | 产品价格: | ¥1980.0 |
| 规格: | 200ul | 产品价格: | ¥2800.0 |
| 产品编号 | bs-20237R |
| 英文名称 | AMPK beta 1/PRKAB1 Rabbit pAb |
| 中文名称 | 腺苷单磷酸活化蛋白激酶β1抗体 |
| 英文别名 | 5 AMP activated protein kinase subunit beta 1; AMPK; AMPK beta 1 chain; AMPKb; HAMPKb; PRKAB1; 5'-AMP-activated protein kinase subunit beta-1; AMP-activated protein kinase beta subunit; protein kinase, AMP-activated, noncatalytic, beta-1; AMPK beta-1 chain; 5'-AMP-activated protein kinase beta-1 subunit; AMPKb; AMPK subunit beta-1; AAKB1_HUMAN; AMPK b1; AMPK-b1. |
| 产品应用 | IHC-P=1:100-500, IHC-F=1:100-500, ICC/IF=1:100-500, IF=1:100-500, Flow-Cyt=2ug/Test Not yet tested in other applications. |
| 交叉反应 | Human, Rat (Chicken) |
| 抗体来源 | Rabbit |
| 免疫原 | KLH conjugated synthetic peptide derived from human AMPK beta 1 |
| 亚型 | IgG |
| 性状 | Liquid |
| 纯化方法 | affinity purified by Protein A |
| 克隆类型 | Polyclonal |
| 理论分子量 | 30 kDa |
| 浓度 | 1mg/ml |
| 储存液 | 0.01M TBS (pH7.4) with 1% BSA, 0.02% Proclin300 and 50% Glycerol. |
| 研究领域 | Cancer > Cancer Metabolism > Metabolic signaling pathway > Integration of energy metabolism Cardiovascular > Lipids / Lipoproteins > Fatty Acids > Metabolism Metabolism > Pathways and Processes > Metabolic signaling pathways > Energy transfer pathways > Integration of energy Metabolism > Pathways and Processes > Metabolic signaling pathways > Lipid and lipoprotein metabolism > Fatty acids Metabolism > Pathways and Processes > Redox metabolism > Fatty acid oxidation Metabolism > Types of disease > Cancer Signal Transduction > Metabolism > Lipid metabolism Signal Transduction > Signaling Pathway > Lipid Signaling > Lipid Kinases |
| 亚基 | AMPK is a heterotrimer of an alpha catalytic subunit (PRKAA1 or PRKAA2), a beta (PRKAB1 or PRKAB2) and a gamma non-catalytic subunits (PRKAG1, PRKAG2 or PRKAG3). Interacts with FNIP1 and FNIP2. |
| 组织特异性 | Highly expressed in kidney, heart, white adipose tissue, lung and spleen. |
| 翻译后修饰 | Phosphorylated when associated with the catalytic subunit (PRKAA1 or PRKAA2). Phosphorylated by ULK1; leading to negatively regulate AMPK activity and suggesting the existence of a regulatory feedback loop between ULK1 and AMPK. |
| 相似性 | Belongs to the 5'-AMP-activated protein kinase beta subunit family. |
| 功能 | Non-catalytic subunit of AMP-activated protein kinase (AMPK), an energy sensor protein kinase that plays a key role in regulating cellular energy metabolism. In response to reduction of intracellular ATP levels, AMPK activates energy-producing pathways and inhibits energy-consuming processes: inhibits protein, carbohydrate and lipid biosynthesis, as well as cell growth and proliferation. AMPK acts via direct phosphorylation of metabolic enzymes, and by longer-term effects via phosphorylation of transcription regulators. Also acts as a regulator of cellular polarity by remodeling the actin cytoskeleton; probably by indirectly activating myosin. Beta non-catalytic subunit acts as a scaffold on which the AMPK complex assembles, via its C-terminus that bridges alpha (PRKAA1 or PRKAA2) and gamma subunits (PRKAG1, PRKAG2 or PRKAG3). |
| 保存条件 | Shipped at 4℃. Store at -20℃ for one year. Avoid repeated freeze/thaw cycles. |
| 注意事项 | This product as supplied is intended for research use only, not for use in human, therapeutic or diagnostic applications. |
| 背景资料 | The protein encoded by this gene is a regulatory subunit of the AMP-activated protein kinase (AMPK). AMPK is a heterotrimer consisting of an alpha catalytic subunit, and non-catalytic beta and gamma subunits. AMPK is an important energy-sensing enzyme that monitors cellular energy status. In response to cellular metabolic stresses, AMPK is activated, and thus phosphorylates and inactivates acetyl-CoA carboxylase (ACC) and beta-hydroxy beta-Methylglutaryl-CoA reductase (HMGCR), key enzymes involved in regulating de novo biosynthesis of fatty acid and cholesterol. This subunit may be a positive regulator of AMPK activity. The myristoylation and phosphorylation of this subunit have been shown to affect the enzyme activity and cellular localization of AMPK. This subunit may also serve as an adaptor molecule mediating the association of the AMPK complex. [provided by RefSeq, Jul 2008]. |
| 应用 | 推荐稀释比例 |
| {IHC-P} | {1:100-500} |
| {IHC-F} | {1:100-500} |
| {ICC/IF} | {1:100-500} |
| {IF} | {1:100-500} |
| {Flow-Cyt} | {2ug/Test} |

Primary Antibody (green line): Rabbit Anti-AMPK beta 1/17 antibody (bs-20237R)
Dilution:2ug/Test;
Secondary Antibody(white blue line): Goat anti-rabbit IgG-FITC
Dilution: 0.5ug/Test.
Isotype control(orange line): Normal Rabbit IgG
Protocol
The cells were fixed with 4% PFA (10min at room temperature)and then permeabilized with 90% ice-cold methanol for 20 min at -20℃, The cells were then incubated in 5%BSA to block non-specific protein-protein interactions for 30 min at room temperature .Cells stained with Primary Antibody for 30 min at room temperature. The secondary antibody used for 40 min at room temperature. Acquisition of 20,000 events was performed.
风险提示:丁香通仅作为第三方平台,为商家信息发布提供平台空间。用户咨询产品时请注意保护个人信息及财产安全,合理判断,谨慎选购商品,商家和用户对交易行为负责。对于医疗器械类产品,请先查证核实企业经营资质和医疗器械产品注册证情况。
文献和实验secondary antibody review -- data from 99 publications
data
【分享】使用韩国BIONEER荧光定量PCR仪发表的文章 (50篇)
9 The use of green fluorescence gene (GFP)-modified rabbit mesenchymal stem cells (rMSCs) co-cultured with chondrocytes in hydrogel constructs to reveal the chondrogenesis of MSCs Han N. Yanga, Ji S. Parka, Kun Nab, Dae G. Wooa, Young D. Kwona, and Keun
Generation of Spatio‐Temporally Controlled Targeted Somatic Mutations in the Mouse
. Berton, T.R., Matsumoto, T., Page, A., Conti, C.J., Deng, C.X., Jorcano, J.L., and Johnson, D.G. 2003. Tumor formation in mice with conditional inactivation of Brca1 in epithelial tissues. Oncogene 22:5415
技术资料暂无技术资料 索取技术资料






